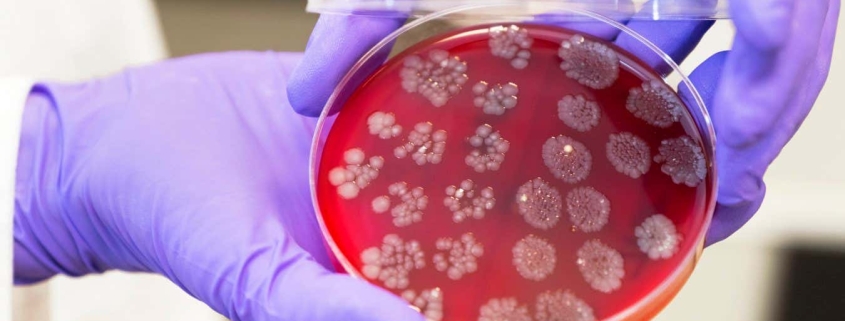
Faecal transplants could boost the effectiveness of cancer treatments

Faecal transplants could boost the effectiveness of cancer treatments
Breakthrough in Cancer Treatment: Faecal Transplants Could Supercharge Immunotherapy for Kidney Cancer Patients
In a stunning medical development that sounds like science fiction but is backed by rigorous science, researchers have discovered that faecal microbiota transplants (FMT) could dramatically improve outcomes for kidney cancer patients undergoing immunotherapy. This groundbreaking approach harnesses the power of gut bacteria to enhance the body’s ability to fight cancer, potentially offering new hope for those who don’t respond to conventional treatments.
The Science Behind the Miracle
The human gut microbiome—trillions of bacteria living in our digestive system—plays a surprisingly crucial role in our overall health, including our immune system’s ability to combat diseases. When it comes to cancer treatment, immunotherapy drugs called checkpoint inhibitors have revolutionized care by helping the immune system recognize and destroy cancer cells. However, these life-saving drugs only work for about 30% of patients.
Enter the unexpected hero: stool samples from successful cancer survivors.
The Groundbreaking Trial
Researchers at the Catholic University of the Sacred Heart in Rome conducted a clinical trial involving 45 adults with advanced kidney cancer who had recently begun treatment with pembrolizumab (a checkpoint inhibitor) combined with axitinib (a drug that cuts off tumors’ blood supply).
The participants were randomly divided into two groups. One group received faecal transplants from a remarkable donor—a man who had achieved complete remission from cancer after receiving checkpoint inhibitors. The other group received a placebo saline solution. The transplants were initially delivered directly to the large intestine via a small tube, followed by oral pills at three and six months.
Results That Defy Expectations
The outcomes were nothing short of extraordinary. Patients who received the faecal transplants experienced cancer stabilization for an average of two years—more than double the nine-month stabilization period seen in the placebo group. Even more impressively, over half of the FMT recipients saw their tumors shrink, compared to only about one-third in the control group.
“This meaningfully strengthens the evidence that the gut microbiome can be therapeutically manipulated to influence immunotherapy outcomes,” noted Hassane Zarour, a cancer immunology expert at the University of Pittsburgh who wasn’t involved in the study.
The Microbiome Connection
But how exactly does this work? Analysis of stool samples revealed that the transplants introduced beneficial bacteria, particularly a species called Blautia wexlerae, which produces short-chain fatty acids known to promote anti-cancer immune cells. The transplants also shifted the balance of existing gut bacteria, reducing harmful inflammation-promoting strains of Escherichia coli while increasing beneficial bacteria like Ruminococcus bromii that support the production of cancer-fighting compounds.
A Broader Revolution in Cancer Care
This isn’t an isolated finding. Another study published this week showed similar success using FMT to enhance checkpoint inhibitors in patients with non-small cell lung cancer. These parallel discoveries suggest that manipulating the gut microbiome could become a powerful tool across multiple cancer types that respond to immunotherapy, including bladder and head and neck cancers.
The Road Ahead
While these results are incredibly promising, researchers emphasize that larger, randomized controlled trials are needed to confirm the findings and establish optimal protocols. The ultimate goal is to identify the specific bacterial strains responsible for the therapeutic effects, potentially allowing scientists to create standardized, laboratory-produced microbial treatments that could be manufactured at scale.
“This could transform how we approach immunotherapy resistance,” says Arielle Elkrief from the University of Montreal. “Instead of resigning patients to treatments that don’t work, we might be able to ‘prime’ their immune systems for success.”
A New Frontier in Medicine
The implications extend far beyond cancer treatment. If manipulating the gut microbiome can enhance immune responses against cancer, could similar approaches help with autoimmune diseases, chronic infections, or even neurodegenerative conditions? The gut-immune connection is proving to be one of the most exciting frontiers in medical research.
For kidney cancer patients who have exhausted conventional options, this research offers a glimmer of hope—a reminder that sometimes, the most powerful medicines come from the most unexpected places. As one researcher put it, “We’re not just treating cancer; we’re reprogramming the body’s natural defenses.”
Tags: #CancerBreakthrough #GutHealth #Immunotherapy #MedicalInnovation #FaecalTransplant #KidneyCancer #MicrobiomeResearch #RevolutionaryTreatment #ScienceFictionBecomesReality #HopeForCancerPatients
Viral Sentences: “Poop transplants could be the future of cancer treatment” | “Scientists discover that stool from cancer survivors can help others beat the disease” | “Your gut bacteria might hold the key to beating cancer” | “The weirdest cancer treatment that actually works” | “From waste to wonder: How feces is fighting cancer” | “Nature’s most unexpected cancer cure” | “The microbiome revolution in oncology” | “Why your poop could save your life” | “Scientists harness gut bacteria to supercharge cancer drugs” | “The $#!+ that could save millions”
,

Leave a Reply
Want to join the discussion?Feel free to contribute!